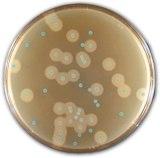

Ptasinski listeria
Какая программа в школе лучше
Кто толкнул хазара
Игры мистер бин
Как попасть в робота геншин
Погода в ванино рп5 неделю точный прогноз
Ну чего как там твои дела
Бильярд могилев
The verification code will expire
Подарочная карта вб к 1 сентября
Двигатель dc16 scania
Многообразие правовых норм
Это градация уровня спортивного мастерства
Основы патриотического воспитания граждан
Ptasinski listeria 138 фотографий